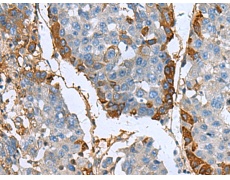
一抗

|
Background: |
This gene encodes an RGD-containing protein that binds to type I, II and IV collagens. The RGD motif is found in many extracellular matrix proteins modulating cell adhesion and serves as a ligand recognition sequence for several integrins. This protein plays a role in cell-collagen interactions and may be involved in endochondrial bone formation in cartilage. The protein is induced by transforming growth factor-beta and acts to inhibit cell adhesion. Mutations in this gene are associated with multiple types of corneal dystrophy. |
|
Applications: |
ELISA, WB, IHC |
|
Name of antibody: |
TGFBI |
|
Immunogen: |
Fusion protein of human TGFBI |
|
Full name: |
transforming growth factor beta induced |
|
Synonyms: |
CSD; CDB1; CDG2; CSD1; CSD2; CSD3; EBMD; LCD1; BIGH3; CDGG1 |
|
SwissProt: |
Q15582 |
|
ELISA Recommended dilution: |
5000-10000 |
|
IHC positive control: |
Human liver cancer |
|
IHC Recommend dilution: |
50-200 |
|
WB Predicted band size: |
75 kDa |
|
WB Positive control: |
Rat liver tissue lysate |
|
WB Recommended dilution: |
500-2000 |


 購物車
購物車 幫助
幫助
 021-54845833/15800441009
021-54845833/15800441009